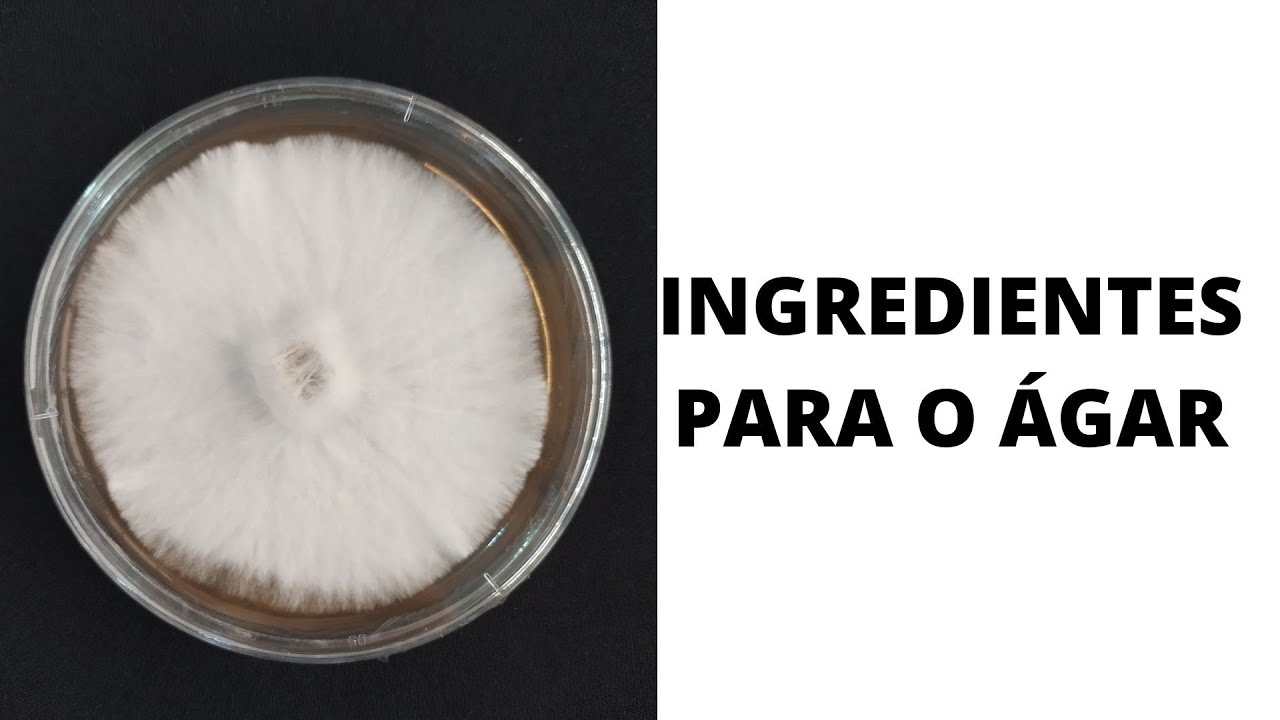
ÁGAR NO CULTIVO DE COGUMELOS: o que utilizar e como preparar?

ÁGAR NO CULTIVO DE COGUMELOS: o que utilizar e como preparar?
Автор: Portal do Cogumelo
Загружено: 2022-03-22
Просмотров: 12675
--------------------------------------------------------------------------------------------------------------------------
Se precisar de:
CULTURAS LÍQUIDAS para seu cultivo, entre no nosso site https://www.portaldocogumelo.com/
Segue o Portal la no instagram @portaldocogumel0
---------------------------------------------------------------------------------------------------------------------------
Olá pessoal do cogumelo! O vídeo de hoje é mais um basicão sobre ágar, para vocês entenderem o que dá de usar para a formulação do meio de cultura sólido e também verem como é extremamente simples preparar a mistura!
A principal fonte de energia dos fungos são os carboidratos, que podem ser classificados entre MONOsacarídeos, OLIGOsacarídeos e POLIsacarídeos. Indo assim em ordem crescente de menos complexo para mais complexo.
IMPORTANTE: No vídeo eu fiz uma pequena confusão onde troquei os OLIGOSACARÍDEOS pelos POLISACARÍDEOS, mas corrigi isso com pequenos avisos ao longo do vídeo, então já peço que me perdoem pelo erro!
O preparo do meio de cultura feito como demonstração é um clássico MEA (malt-extract agar).
Links de ágar alimentício bom para produzir seu meio de cultura:
1) https://produto.mercadolivre.com.br/M...
2) https://produto.mercadolivre.com.br/M...
Por favor coloquem suas dúvidas nos comentários que talvez elas possam virar um vídeo um dia!!
Espero que esse simples vídeo tenha clareado a cabeça de alguns de vocês, seja lá com o que for.
Mando para vocês um grande abraço pessoal! E desejo-lhes um ótimo cultivo!
Доступные форматы для скачивания:
Скачать видео mp4
-
Информация по загрузке:



















